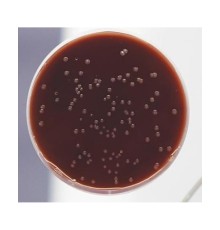

Не является лекарственным (фармацевтическим) препаратом. Не является БАД.
Не предназначен для проведения любых медицинских исследований или процедур.
Продажу химических реактивов осуществляем только юридическим лицам.
Предназначена для приготовления жидких и плотных питательных сред, используемых при проведении микробиологических исследований.
Представляет собой мелкодисперсный гомогенный, гигроскопичный, светочувствительный порошок желтого цвета.
Состав (в пересчете на 1 л готовой среды):
• Пептон ферментативный сухой - 13,0 г
• Натрия хлорид- 6,6 г
• Лактоза - 10,0 г
• Сульфанол - 2,2 г
• Бромтиловый синий - 0,05 г
• Натрий углекислый - 0,28 г.
Жидкая питательная среда для выделения и дифференциации энтеробактерий по признаку ферментации лактозы при санитарном контроле пищевых продуктов и объектов внешней среды.
Сухую среду в количестве 32 г размешать в 1 л воды очищенной, кипятить до полного растворения среды, профильтровать. Вновь довести до кипения и разлить в стерильные пробирки. Готовая к употреблению среда должна быть прозрачной зеленовато-синего цвета. Готовую среду до использования можно хранить в темном месте не более 7 суток при температуре 2-8°C.
Посевы исследуемых образцов инкубировать 44-48 часов при температуре 37°C. Рост микроорганизмов, ферментирующих лактозу, приводит к диффузному помутнению среды и меняет цвет среды на желтый. Рост микроорганизмов, не ферментирующих лактозу, приводит только к диффузному помутнению среды.
Потенциальный риск применения набора – класс 1 (Приказ МЗ РФ № 4н от 06.06.2012 г.) Меры предосторожности при использовании по назначению готовых питательных сред – соблюдение требований СП 1.32322-08 Безопасность работы с микроорганизмами III-IV групп патогенности (опасности) и гельминтами и возбудителями паразитарных инфекций. Утилизация сухих сред с истекшим сроком хранения и использованных готовых питательных сред – в соответствии с требованиями СанПиН 2.1.7.728-99 Правила сбора, хранения и удаления отходов лечебно-профилактических учреждений.
Хранение - в упаковке предприятия-изготовителя в сухом, защищенном от света месте при температуре от 2°C до 25°C. Замораживание не допускается. Транспортирование - при температуре от 2°C до 25°C.Замораживание не допускается.Срок годности – 2 года. Среды с истекшим сроком годности применению не подлежат.
Стоимость дана с учетом НДС 10% за 1 кг среды.
Нет отзывов об этом товаре.
Нет вопросов об этом товаре.
Доставка заказов осуществляется в любые регионы Российской Федерации и страны СНГ.
Цены на нашем сайте указаны с учетом НДС (20% либо 10%).
Оплата заказов производится только в безналичной форме на расчетный счет в рублях Российской Федерации на основании выставленного Счета.
Для бюджетных организаций и государственных структур предусмотрены особые условия оплаты.
Постоянным клиентам предоставляются скидки и индивидуальный порядок расчетов.
Внимание! В связи с нестабильным курсом валют и изменением цен у производителей, просим окончательную стоимость продукции уточнять у наших менеджеров.
Варианты доставки:
Самовывоз со склада в городе Клин
Адрес выдачи: Московская область, г. Клин, ул. Захватаева, д. 4, офис 101
Контактный телефон: +7 (977) 407-05-96
Доставка по Клину и Клинскому району – бесплатно
Доставка по Москве – 1 500 рублей
Доставка любыми транспортными компаниями, службами экспресс-доставки. Стоимость рассчитывается индивидуально для каждого заказа в соответствии с установленными тарифами транспортной компании. Все грузы застрахованы.
Компания "КомплектСнаб является официальным поставщиком от производителя ООО . Вы всегда можете получить бесплатную консультацию по продукции, получить КП и задать вопросы по подбору аналогов продукции.